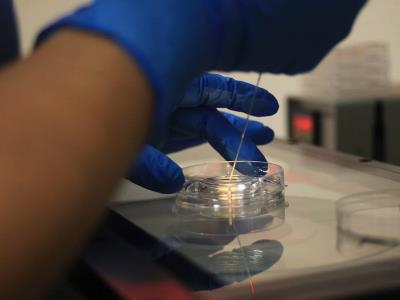

Cada vez más parejas estadounidenses cruzan a Ciudad Juárez, en la frontera de México, para buscar un embarazo con tratamientos que van desde lo psicológico hasta los más modernos sistemas in vitro, con un precio que es apenas una tercera parte de lo que cuesta en Estados Unidos.
Una de las principales razones, explican especialistas de la ciudad fronteriza con Texas, es que en Juárez el costo de este servicio es de apenas una tercera parte o la mitad de lo que cuesta en Estados Unidos, aunado a la calidad del servicio.
«Aproximadamente el 30 % de las pacientes en la ciudad son de Estados Unidos, de El Paso y áreas vecinas, fácilmente son centenares y podríamos alcanzar el millar al año», expone a EFE la obstetra y bióloga de la reproducción Laura Adriana Guerrero de Iniciar, un centro de fertilidad con más de 12 especialistas y equipo de última generación.
«Muchas de las pacientes son hispanas, latinas o mexicanas de Juárez que se fueron a vivir a Estados Unidos y viven allá, pero buscan atención con médicos mexicanos por economía o por servicio» agrega la especialista.
La médica detalla que la tasa de infertilidad ha aumentado por una tendencia al alza en la edad en la que las parejas buscan un hijo, así como los hábitos de vida de los estadounidenses y de la frontera.
«Los varones que vienen de Estados Unidos son pacientes que tienen cierto grado de complejidad porque vienen muy expuestos a químicos, y las mujeres están con procesos hormonales, como obesidad, síndrome metabólico, resistencia a la insulina, tiroides, son de los que más comúnmente estoy tratando», explica Guerrero.
Modernidad reproductiva en la frontera
Nancy García, administradora del Centro de Fertilidad Iniciar, afirma que el atractivo de Juárez no es solo el precio, sino que existen los más modernos procedimientos.
«El tratamiento de alta complejidad es un in vitro. Se estimula la paciente con medicamento entre 10 y 12 días, cuando ya se tienen los ovocitos se extraen en un quirófano, un procedimiento ambulatorio de 15 minutos, unas 4 horas en el hospital, se fecundan ese mismo día, pasan 5 días y se congelan y luego se puede hacer la transferencia embrionaria al útero de la paciente», expone.
La experta agrega que el tratamiento de baja complejidad es una inseminación artificial que ocurre con una dosis baja de medicamento, y es un procedimiento parecido al proceso de fertilidad natural que se hace en el mismo consultorio.
«El costo del tratamiento aquí es 50 % menor que en Estados Unidos, allá cuesta alrededor de unos 350,000 pesos o 400,000 pesos (entre 17,492 dólares y 23,323 dólares), aquí menos de 150,000 pesos (8.746 dólares)», explica la administradora.
Mientras que el especialista en genética clínica Pedro Rodríguez Gómez sostiene que «en cuanto a tecnología no hay una ciudad en México ni en la mayor parte del mundo que concentre todas estas tecnologías» y los «procedimientos que se hacen en todo el mundo» están en Juárez.
«Tenemos la misma tecnología: micromanipuladores, cámaras de alto flujo, incubadoras, embriología, tecnología para hacer biopsias genéticas embrionarias, tenemos la tecnología de alta gama», abunda.
Laura García, embrióloga que trabaja en fertilidad desde que estudiaba medicina a finales de los 90, señala que la ciudad tiene al menos 4 clínicas con tecnología y especialistas de alta gama, por lo que Juárez es atractivo para las parejas que buscan un embarazo.
Dice que los pacientes llegan a Juárez buscando mejor precio, pero también el mejor servicio que ofrecen los especialistas mexicanos.
«Es muy bonito ser parte de este proceso, de a través de la ciencia poder ayudarle a la gente a poder concebir un hijo, cuando la ciencia puede ayudar con esto se siente una satisfacción muy grande», añade.